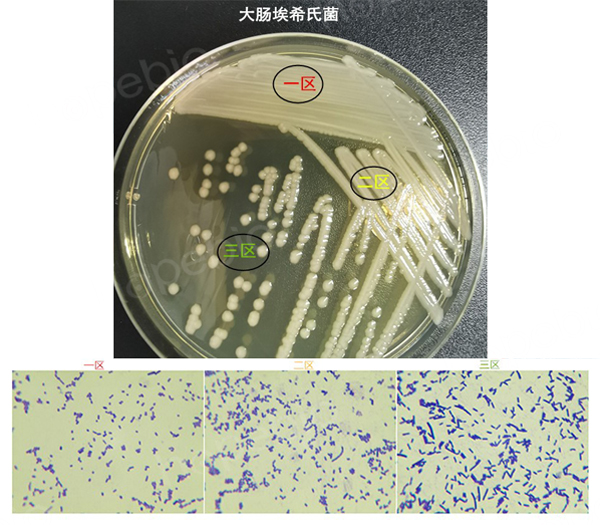

海博微信公众号
海博天猫旗舰店




一、简介:
在进行微生物试验时,菌种的挑选特别重要。除了要选对菌种外,还要注意对菌体生长状态的把握。
通常来说很多标准中都对试验用菌有要求,有的会明确要求用培养多长时间的菌进行后续试验,食品检验标准中经常可以看到这类描述,如“挑取单个典型黑色菌落接种到FTG培养基,36℃±1℃培养18h~24h,用于后续的确证试验。”“取生长旺盛的FTG培养液1 mL接种于含铁牛乳培养基……”(参考GB4789.13 食品微生物学检验 产气荚膜梭菌检验),而有些标准则不厌其烦地强调“新鲜培养物”,如《中国药典》中,在培养基灵敏度检查部分,就再三强调这一点,“菌液制备接种金黄色葡萄球菌、铜绿假单胞菌、枯草芽孢杆菌的新鲜培养物至胰酪大豆胨液体培养基中或胰酪大豆胨琼脂培养基上,接种生孢梭菌的新鲜培养物至硫乙醇酸盐流体培养基中,30°C~35°C培养18h~24h;接种白色念珠菌的新鲜培养物至沙氏葡萄糖液体培养基中或沙氏葡萄糖琼脂培养基上”(参考《中国药典》 2020版 第157页)……
二、试验说明
标准中之所以这么要求,是希望能用最优状态的菌种,做出最明显的效果,保证试验结果的可靠性。本文以平板上不同区域菌体的形态差别对此问题进行说明:分别将大肠埃希氏菌(典型的革兰氏阴性菌)和金黄色葡萄球菌(典型的革兰氏阳性菌),在TSA平板上三区划线、培养,然后将每种菌分别从同一平板上的三个区域挑菌、涂片、镜检,观察它们的菌体形态,为了方便观察,涂片后先用结晶紫进行染色,再进行镜检观察。结果如下(图1、图3):
图1 大肠埃希氏菌在平板上三区划线培养后的菌落及菌体状态
大肠埃希氏菌(Escherichia coli,E.coli),革兰氏阴性短杆菌,大小0.5微米~0.5×3微米。从镜检结果不难发现,同一平板上不同区域长出的菌体,形态差别非常明显:一区的菌体为短杆状甚至点状,有些菌体已经明显衰亡;二区杆状形态的菌体明显增多,且比一区的杆状菌体较长、较粗;三区菌体全部为较长的杆状且非常粗壮,与对数生长期菌体在扫描电镜下的状态基本一致(如图2)。

图2 扫描电镜下对数生长期的大肠埃希氏菌形态
金黄色葡萄球菌,作为一种典型的革兰氏阳性菌,三个区域内菌体差异虽然没有那么显著,但也呈现出同样的规律(如图3)。
图3 金黄色葡萄球菌在平板上三区划线培养后的菌落及菌体状态
三、讨论:
同一平板的不同区域的同一种菌呈现不同的形态,可以直观解释为一区菌体密度太大,二区次之,三区菌体密度较小所致。其根本原因在于,同等面积的区域上菌体密度过大,会造成菌体间营养竞争,有些菌体因为营养不良生长较差或长不出来,同时区域内的优势菌株还可能产生一些细胞毒素等,遏制其它菌体的生长。而三区内的菌营养比较充足,生长几乎不受影响,所以菌体状态最好。
我们做实验时,通常都会要求用生长状态最好的菌,有时候用新鲜菌体能做出很明显的阳性结果,但如果菌体不新鲜,就会形成假阴性结果(参考氧化酶试验的操作方法及注意要点)。
综上所述,在微生物试验过程中,无论制作菌液还是进行菌株鉴定等,一定要注意菌体的新鲜度和菌体的健壮程度,尽量选用新鲜健壮的菌体进行试验。如果是在平板上挑菌,我们通常挑取三区生长的单菌落进行后续试验。
相关标准:
注:本文属海博生物原创,未经允许不得转载。
下一篇:关于丁酸梭菌的检验原理及方法
| 相关文章: | ||
